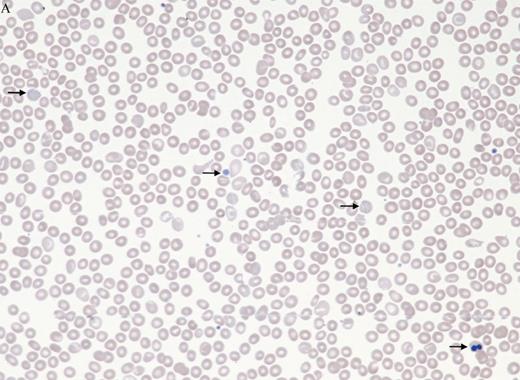
Peripheral blood smear in intramedullary hemolysis in myelodysplastic syndromes image challenge. / Peripheral blood smear.
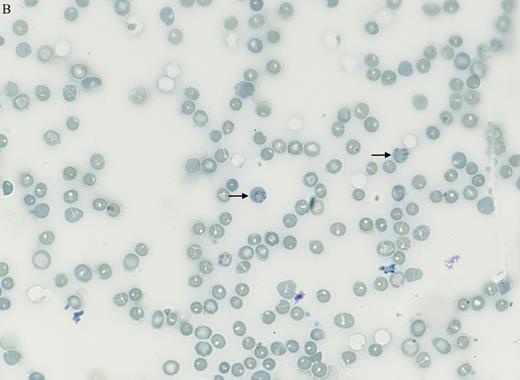
Manual supravital staining of peripheral blood smear at 60 x magnification. / Manual supravital staining of PB smear.

A 68-year-old man with Gilbert's syndrome was referred for evaluation of fatigue and pancytopenia. Examination revealed scleral icterus. Automated blood counts reported a white blood cell count of 1.8 × 109/L; hemoglobin, 10.4 g/dL; mean cell volume, 99 fL; platelet count, 59 × 109/L; nucleated red blood cells (NRBCs), 11 percent; reticulocytes, 10 percent,; and absolute reticulocyte count, 342 × 109/L (by flow cytometry; Sysmex XN hematology analyzer). Additional laboratory results showed total bilirubin at 7 mg/dL; direct bilirubin, 0.39 mg/dL; and haptoglobin undetectable, with a negative direct antiglobulin test for IgG (including low affinity IgG), C3, IgM, and IgA. No iron, vitamin B12, copper, paroxysmal nocturnal hemoglobinuria clone or G6PD deficiency was detected. Peripheral blood (PB) smear is shown in Figure 1 (40×). Bone marrow evaluation demonstrated 95 percent cellularity, erythroid hyperplasia, trilineage dysplasia, and no increase in blasts or abnormal karyotype. A myeloid somatic mutation next-generation sequencing panel showed no mutations.
Peripheral blood smear in intramedullary hemolysis in myelodysplastic syndromes image challenge
Peripheral blood smear.
Peripheral blood smear.
A. Direct antiglobulin (Coombs) test–negative autoimmune hemolytic anemia
B. Hypersplenism due to Gilbert's syndrome
C. Intramedullary hemolysis from myelodysplastic syndrome
D. Microangiopathic hemolytic anemia
Sorry, that was not the preferred response.
Correct!
Manual supravital staining of peripheral blood smear at 60 x magnification
Manual supravital staining of PB smear.
Manual supravital staining of PB smear.
Erythrocyte findings on the PB smear include macrocytosis, basophilic stippling, and rare NRBCs, but no polychromasia, spherocytes, or schistocytes to suggest peripheral hemolysis. Platelet findings include large and hypogranular forms. Manual supravital staining of PB smear (Figure 2, 60×) revealed only 1.4 percent reticulocytes. Review of reticulocyte scattergram (Figure 3) showed poor separation of mature erythrocytes, NRBCs, and reticulocytes by the analyzer.
Figure showing review of reticulocyte scattergram
Review of reticulocyte scattergram.
Review of reticulocyte scattergram.
In addition to peripheral hemolysis, low haptoglobin and indirect hyperbilirubinemia may also be seen in patients with intramedullary hemolysis and ineffective erythropoiesis, herein due to myelodysplastic syndrome (MDS) mimicking hemolytic anemia.1 Patients with ineffective erythropoiesis and intramedullary hemolysis due to MDS lack peripheral reticulocytosis in comparison to patients with peripheral hemolysis (e.g., autoimmune and microangiopathic hemolytic anemias).1 Evaluation of blood smear, supravital staining, and the scattergram are key features since basophilic stippling, large platelets, and NRBCs may be miscounted as reticulocytes by automated analyzers.2 Hyperbilirubinemia can be accentuated in patients with Gilbert’s syndrome who have an inherited condition causing impaired bilirubin glucuronidation. Gilbert’s syndrome does not cause anemia or hypersplenism.
References
References
Drs. Shomali, Kurzer, and Greenberg indicated no relevant conflicts of interest.